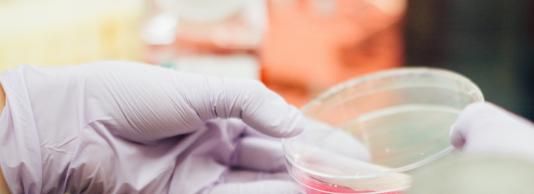
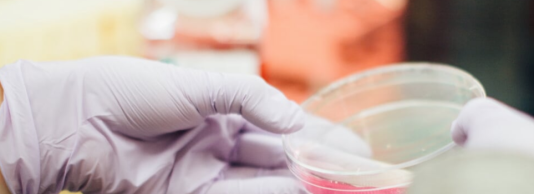

|
Data ultimei actualizări: 03/07/2026
Deadline: 08/07/2026

Stagii remunerate la Banca de Dezvoltare a Consiliului Europei din Paris.
Data ultimei actualizări: 02/07/2026
Deadline: 09/07/2026

Oportunităţi de stagiu de practică în cadrul Băncii Centrale Europene.
Data ultimei actualizări: 01/07/2026
Deadline: 10/07/2026

Oportunități în cadrul Delegațiilor UE din întreaga lume pentru studenți, tineri absolvenți și funcționari publici stagiari.
Data ultimei actualizări: 07/07/2026
Deadline: 11/07/2026

Un festival educațional hibrid pentru elevi, studenți și părinți interesați de studii internaționale și oportunități academice în întreaga lume.
Data ultimei actualizări: 17/06/2026
Deadline: 15/07/2026

Stagii plătite cu o durată de 6 până la 12 luni, disponibile permanent pentru studenții și absolvenții europeni
Data ultimei actualizări: 03/07/2026
Deadline: 19/07/2026

Oportunități de stagiu de practică între regiunile europene.
Data ultimei actualizări: 01/07/2026
Deadline: 19/07/2026

Apel pentru tineri lideri și promotori ai schimbării să susțină dialogul intercultural și să producă un impact semnificativ în comunitățile lor.
Data ultimei actualizări: 08/05/2026
Deadline: 31/07/2026

Celebrează articolele jurnalistice realizate de jurnaliști profesioniști din UE.
Data ultimei actualizări: 07/07/2026
Deadline: 31/07/2026

Imaginează-ți că te trezești și nu mai ai curent electric. Ia-ți telefonul sau camera foto și trimite un videoclip scurt în care să ne împărtășești ideile tale despre cum se poate consolida reziliența
Data ultimei actualizări: 08/05/2026
Deadline: 04/08/2026

Înscrie-te în competiția Capitala Europeană a Inovării și intră în cursa pentru 1 milion de euro.
Data ultimei actualizări: 29/06/2026
Deadline: 12/08/2026

Oferă oportunități profesionale axate pe carieră în întreaga lume pentru a câștiga experiență și a crește șansele tinerilor de a găsi un loc de muncă.
Data ultimei actualizări: 19/06/2026
Deadline: 30/08/2026
Dă frâu liber creativității tale pentru a salva planeta.
Data ultimei actualizări: 28/04/2026
Deadline: 31/08/2026

Oportunitate anuală pentru orașele mediteraneene de a deveni capitale europene.
Data ultimei actualizări: 02/04/2026
Deadline: 01/09/2026

Burse de studiu în Germania.
Data ultimei actualizări: 01/07/2026
Deadline: 20/09/2026

Tinerii sunt invitați să își prezinte opiniile cu privire la antreprenoriat.
Data ultimei actualizări: 22/05/2026
Deadline: 01/10/2026

Sprijină proiectele de participare locală, națională și transnațională dezvoltate de grupuri informale de tineri și/sau de organizații de tineret.
Data ultimei actualizări: 02/04/2026
Deadline: 01/10/2026

support organisations active in the fields of education, training and youth carry out Vocational Education and Training Traineeships abroad up to 12 months.
Data ultimei actualizări: 31/03/2026
Deadline: 01/10/2026

În cadrul acestei acțiuni, organizațiile și grupurile informale de tineri pot primi sprijin pentru a derula proiecte care aduc împreună tineri din țări diferite pentru a învăța în afara educației formale.
Data ultimei actualizări: 19/06/2026
Deadline: 07/10/2026

Titlu acordat unui oraş european pentru o perioadă de un an, timp în care acest oraş va avea ocazia să-şi promoveze viaţa și dezvoltarea culturală, socială, politică şi economică în domeniul tineretului.
Data ultimei actualizări: 06/07/2026

Banca Europeană de Investiții (BEI) este instituția de finanțare a Uniunii Europene. Sarcina sa este de a contribui la integrarea, dezvoltarea echilibrată și coeziunea economică și socială a țărilor membre.
Data ultimei actualizări: 05/07/2026

Ești gata să ai un impact real și să te conectezi cu lideri inspiraționali din întreaga lume?
Data ultimei actualizări: 01/07/2026

Oportunitate pentru tinerii profesioniști din domeniul cinematografiei.
Data ultimei actualizări: 30/06/2026

Oportunitatea de a participa la Summit-ul The World Around 2026.
Data ultimei actualizări: 30/06/2026

Finanțare de 60.000 EUR pentru persoane fizice și instituții active în domeniul drepturilor omului.
Data ultimei actualizări: 30/06/2026

Reuniune a tinerilor care implementează sau au implementat un proiect de solidaritate.
Data ultimei actualizări: 30/06/2026

ECML recrutează candidaţi de două ori pe an pentru un stagii cu durata de 6 luni.
Data ultimei actualizări: 30/06/2026

Invită tinerii să trimită scurtmetraje creative pe teme sociale.
Data ultimei actualizări: 29/06/2026

Platformă internațională care pune în legătură voluntarii (workawayers) și gazdele (hosts) acestora.
Data ultimei actualizări: 23/06/2026

Stagii remunerate la Asociația Europeană a Studenților la Drept.
Data ultimei actualizări: 23/06/2026

Oportunitate pentru tineri europeni să își descopere și să își exploreze continentul și să devină ambasadorii unei Europe unite.
Data ultimei actualizări: 22/06/2026

Oferă persoanelor posibilitatea de a afla mai multe despre activitățile agenției și de a-și pune în practică cunoștințele și abilitățile, contribuind la misiunea Europol.
Data ultimei actualizări: 17/06/2026

Program online gratuit de leadership pentru tinerii din Europa.
Data ultimei actualizări: 17/06/2026

Stagii de practică ONU în Tokio.
Data ultimei actualizări: 15/06/2026

Premii în bani pentru studenți din întreaga lume pasionați de lumea cuantică.
Data ultimei actualizări: 11/06/2026

Fă-ți auzită vocea în ceea ce privește problemele legate de ocean.
Data ultimei actualizări: 06/06/2026

Aplică pentru a deveni noua Capitală Europeană a Voluntariatului.
Data ultimei actualizări: 06/06/2026

Finanțare pentru dialogul intercultural între organizațiile din zona mediteraneană.
Data ultimei actualizări: 04/06/2026

Scutire integrală de 100% a taxelor de școlarizare pentru a studia la Universitatea Bocconi.
Data ultimei actualizări: 04/06/2026

Oportunitate pentru creatorii europeni de schimbare cu soluții îndrăznețe pentru o provocare socială sau de mediu.
Data ultimei actualizări: 31/05/2026
Program de dezvoltare cu durată de 3 ani pentru a lucra la NATO.
Data ultimei actualizări: 31/05/2026

Burse în valoare de 10.000 EUR pentru studii de masterat în străinătate.
Data ultimei actualizări: 31/05/2026

Program de studiu pentru jurnaliștii locali și regionali din Uniunea Europeană
Data ultimei actualizări: 31/05/2026

Organizații publice sau private din întreaga lume sunt invitate să prezinte inițiative care vizează rezolvarea problemelor de mediu și consolidarea democrației în întreaga lume.
Data ultimei actualizări: 29/05/2026
Premiu pentru proiecte educaționale privind utilizarea inteligenței artificiale.
Data ultimei actualizări: 26/05/2026

O experiență remunerată, cu durată de cinci luni la Euradio, două sesiuni de stagii pe an.
Data ultimei actualizări: 25/05/2026

Reuniune anuală care urmărește promovarea soluțiilor concrete de guvernanță globală.
Data ultimei actualizări: 24/05/2026

Oportunitate pentru tinerii europeni.
Data ultimei actualizări: 20/05/2026
Sesiune interactivă despre activism și politicile UE.
Data ultimei actualizări: 20/05/2026

Oportunitate pentru universități de a organiza cursuri de formare în domeniul mobilității forței de muncă în UE.
Data ultimei actualizări: 18/05/2026

Concurs video pentru a câștiga 2 abonamente interrail și multe altele.
Data ultimei actualizări: 17/05/2026
Oportunitate pentru tinerii inovatori de a câștiga până la 10.000 de euro.
Data ultimei actualizări: 15/05/2026

Bursă de studii pentru semestrul de toamnă 2024, cu o valoare de până la 5.000 de euro.
Data ultimei actualizări: 13/05/2026

Alătură-te discuțiilor cu comisarul european Micallef pentru a-ți spune părerea cu privire la strategia pentru tineret.
Data ultimei actualizări: 13/05/2026

Recunosc creativitatea și inovația producțiilor muzicale pentru publicul tânăr.
Data ultimei actualizări: 12/05/2026

Conectează tinerii cu factorii de decizie și liderii din Asia și din UE.
Data ultimei actualizări: 11/05/2026
Participă la conferința finală a proiectului „Europe on Track 12” de la Bruxelles.
Data ultimei actualizări: 06/05/2026

Cinci granturi în valoare de 10.000 de euro pentru femei care studiază în domeniul științelor economice, statistică, inginerie sau informatică.
Data ultimei actualizări: 06/05/2026

Oportunitate pentru studenții absolvenți/ absolvenți și candidații recent absolvenți care caută o experiență de învățare practică în domenii legate de mandatul și activitățile OIM.
Data ultimei actualizări: 04/05/2026

Oferă tinerilor antreprenori posibilitatea de a lucra pentru o lume mai pașnică și mai durabilă.
Data ultimei actualizări: 04/05/2026

Stagii plătite la Agenţia pentru Drepturi Fundamentale a UE.
Data ultimei actualizări: 01/05/2026

Testează-ți cunoștințele despre Europa și câștigă o excursie.
Data ultimei actualizări: 01/05/2026

Oferă posibilitatea tinerilor cu vârsta cuprinsă între 18 și 30 de ani, care vorbesc fluent limba engleză, să fie formatori de limba engleză într-o tabără de vară pentru copii.
Data ultimei actualizări: 30/04/2026

Călătorește în timp și prin diferite țări, descoperind poveștile ascunse ale istoriei migrației în Europa.
Data ultimei actualizări: 30/04/2026

Programul de leadership cu durata de un semestru care se desfășoară în campusul tău.
Data ultimei actualizări: 28/04/2026

Susține inițiativele culturale transfrontaliere care consolidează solidaritatea europeană.
Data ultimei actualizări: 24/04/2026

Bursă pentru un MBA în străinătate.
Data ultimei actualizări: 23/04/2026

Oferă oportunitatea organizațiilor să depună proiecte de ajutor umanitar.
Data ultimei actualizări: 20/04/2026

Oportunitate pentru tinerii care aduc schimbare.
Data ultimei actualizări: 19/04/2026

Cursuri de formare în domeniul democrației pentru tineri activiști și lucrători în domeniul tineretului.
Data ultimei actualizări: 19/04/2026

Webinarii privind consolidarea participării tinerilor la procesul decizional local.
Data ultimei actualizări: 19/04/2026

Apelul susține designul, implementarea și evaluarea cursurilor de formare naționale sau regionale pentru formatori și/sau multiplicatori privind educația în domeniul drepturilor omului în rândul tinerilor.
Data ultimei actualizări: 17/04/2026

Concurs de astronomie pentru elevii de liceu și studenți.
Data ultimei actualizări: 16/04/2026

Oportunități pentru tineri de a face voluntariat în siturile Patrimoniului Mondial.
Data ultimei actualizări: 15/04/2026

Curs de formare pentru animatori de tineret privind cooperarea în echipă.
Data ultimei actualizări: 15/04/2026

Oportunitate pentru organizațiile de tineret de a organiza activități în cooperare cu Centrele Europene de Tineret.
Data ultimei actualizări: 15/04/2026

Oportunitățile se adresează proaspeților absolvenți de studii superioare în domenii științifice precum chimie, toxicologie, biologie, științe și tehnologii de mediu, precum și în domeniul administrativ, cum ar fi drept, comunicare, finanțe, resurse umane și TIC.
Data ultimei actualizări: 13/04/2026
Fii un susținător al cauzei sănătății mintale.
Data ultimei actualizări: 06/04/2026

Apel pentru tinerii creatori să-și prezinte lucrările creative despre un viitor rezilient la schimbările climatice.
Data ultimei actualizări: 06/04/2026

Oportunitate de a câștiga 1.500 de euro pentru inițiativa ta de sensibilizare cu privire la ocean.
Data ultimei actualizări: 03/04/2026

Contribuie la elaborarea politicii globale și reprezintă tinerii europeni la Națiunile Unite.
Data ultimei actualizări: 03/04/2026

WWOOF este o platformă prin intermediul căreia se poate face voluntariat în ferme organice.
Data ultimei actualizări: 02/04/2026

Antrenează-te și participă la Campionatul Mondial de Dezbateri de la Padova, Italia.
Data ultimei actualizări: 02/04/2026

Învață despre rolul tinerilor în viața democratică.
Data ultimei actualizări: 02/04/2026

Oportunitate pentru elevii de liceu și studenți de a câștiga până la 1500 USD.
Data ultimei actualizări: 02/04/2026

Oportunitate de a contribui la dialogul privind problema locuințelor cu comisarul Dan Jørgensen.
Data ultimei actualizări: 02/04/2026

Program de formare online care încurajează luarea de măsuri în fața provocărilor globale.
Data ultimei actualizări: 02/04/2026

Un curs internațional SALTO de 4 zile, cu finanțare integrală, destinat tinerilor cu vârste cuprinse între 15 și 20 de ani, implicați în activități locale pentru tineret.
Data ultimei actualizări: 02/04/2026

Premiul UE care recunoaște proiectele care dezvoltă competențe ecologice pentru un viitor durabil.
Data ultimei actualizări: 02/04/2026

Apel pentru promovarea limbii și culturii franceze în școlile germane.
Data ultimei actualizări: 02/04/2026

Concurs la nivel european care acordă finanțare pentru a ajuta tinerii să lanseze un proiect civic.
Data ultimei actualizări: 02/04/2026
Program finanțat integral pentru antreprenori sociali axați pe tineret.
Data ultimei actualizări: 02/04/2026
Vizită de studiu pentru lucrătorii din domeniul tineretului, cu scopul de a implica tinerii în procesul decizional și în participarea la viața rurală.
Data ultimei actualizări: 02/04/2026

Webinarii online despre transformarea digitală în voluntariat.
Data ultimei actualizări: 02/04/2026

Stagii remunerate în domeniul politicilor UE, advocacy, cercetare și proiecte.
Data ultimei actualizări: 02/04/2026

Curs online care acoperă cadrele juridice, libertatea de exprimare și modul de navigare în lumea digitală.
Data ultimei actualizări: 02/04/2026

Apel pentru artiști care doresc să participe la sesiunea Young Audiences Music din Danemarca.
Data ultimei actualizări: 02/04/2026

Program de formare hibrid în domeniul statului de drept.
Data ultimei actualizări: 02/04/2026

Cerere de propuneri pentru sprijinirea soluțiilor inovatoare de îmbunătățire a competențelor în domeniul educației mediatice.
Data ultimei actualizări: 02/04/2026

Apel către organizațiile dornice să consolideze inovarea europeană în domeniul STEM.
Data ultimei actualizări: 02/04/2026

Oferă organizațiilor oportunități de cooperare internațională între sectoare.
Data ultimei actualizări: 02/04/2026

Consolidarea capacității în domeniul proiectelor pentru tineret reprezintă proiecte de cooperare internațională bazate pe parteneriate multilaterale între organizații active în domeniul tineretului
Data ultimei actualizări: 02/04/2026

Împărtășește-ți cele mai bune idei pe tema „Cultura sustenabilității”.
Data ultimei actualizări: 02/04/2026

Sprijin financiar pentru tinerii lideri în domeniul justiției climatice cu vârsta de 35 de ani.
Data ultimei actualizări: 02/04/2026

Alătură-te dialogului tinerilor cu Mairead McGuinness despre viitorul finanțelor.
Data ultimei actualizări: 02/04/2026

Organizațiile de tineret primesc sprijin pentru a stabili parteneriate transfrontaliere.
Data ultimei actualizări: 02/04/2026

Susține proiecte pe scară largă având drept scop desfășurarea de intervenții cu impact puternic pe termen scurt care abordează provocări societale în domenii de politică definite la nivelul UE.
Data ultimei actualizări: 02/04/2026

Oferă finanțare și sprijin profesional pentru cercetare și pentru redactarea unui material pe un subiect de importanță regională și europeană.
Data ultimei actualizări: 02/04/2026

Oportunitate pentru profesioniști din domeniul artelor.
Data ultimei actualizări: 02/04/2026

Sprijină organizaţiile și organismele publice pentru a organiza evenimente majore sportive la nivel european care promovează activitățile Uniunii Europene în domeniul sportului.
Data ultimei actualizări: 02/04/2026

Sprijină organizațiile active în domeniile educației, formării și tineretului care desfășoară activități de mobilitate a studenților pentru studiu și stagii.
Data ultimei actualizări: 02/04/2026

Stagii de practică de 3-6 luni la Agenţia Europeană pentru Siguranţă Maritimă.
Data ultimei actualizări: 02/04/2026

Voluntariat pentru mediu
Data ultimei actualizări: 12/03/2026
Recompensează promovarea educației de calitate și a învățării pe tot parcursul vieții la nivel local.
Data ultimei actualizări: 10/03/2026

Oportunitate pentru tinerii romi din toată Europa.
Data ultimei actualizări: 03/03/2026

Consiliul Europei – Grupul de cooperare pentru combaterea abuzului şi a traficului ilicit de droguri (Grupul Pompidou) acordă o dată la 2 ani Premiul european pentru prevenirea consumului de droguri pentru trei proiecte ce urmăresc prevenirea consumului de droguri în rândul tinerilor.
Data ultimei actualizări: 17/02/2026

Oportunități de voluntariat pe termen scurt sau tabere de lucru pentru orice persoană indiferent de vârstă și background.
Data ultimei actualizări: 17/02/2026

Oportunitate de voluntariat pe termen lung sau schimburi pentru a efectua un stagiu în străinătate cu o durată cuprinsă între 1 și 12 luni pentru persoane indiferent de vârstă și background.
Data ultimei actualizări: 17/02/2026
Oportunități de voluntariat internațional.
Data ultimei actualizări: 16/02/2026
Eveniment care precede Dialogul european privind guvernanța Internetului.
Data ultimei actualizări: 16/02/2026

Apel pentru 40 de delegați aflați la începutul carierei, care să se alăture următoarei generații de lideri în domeniul conservării oceanelor și al climei.
Data ultimei actualizări: 15/02/2026

Forumul Tinerilor Lideri Europeni va reuni tineri lideri din toată Europa.
Data ultimei actualizări: 15/02/2026

Oportunitate pentru apărători ai drepturilor omului din afara UE.
Data ultimei actualizări: 10/02/2026

Devino un factor de schimbare.
Data ultimei actualizări: 09/02/2026

Sprijină tinerii inovatori cu idei sau proiecte de sustenabilitate.
Data ultimei actualizări: 04/02/2026

Sprijin financiar pentru colaborări transfrontaliere în domeniul mass-media, în vederea consolidării inovării și sustenabilității în sectorul știrilor.
Data ultimei actualizări: 04/02/2026

Apel care vine în sprijinul sectoarelor mass-media democratice pentru adaptarea digitală și consolidarea pluralismului.
Data ultimei actualizări: 03/02/2026
Rețele tematice în învățământul superior pentru a discuta rezultatele cercetării.
Data ultimei actualizări: 03/02/2026
Rețele în învățământul superior pentru a oferi feedback cu privire la practici inovatoare.
Data ultimei actualizări: 03/02/2026

Reprezintă un grant al UE pentru un program de predare sau un curs de scurtă în domeniul studiilor Uniunii Europene într-o instituție de învățământ superior.
Data ultimei actualizări: 03/02/2026

Reprezintă un grant UE pentru crearea de puncte focale de competență și cunoștințe pe subiecte legate de Uniunea Europeană.
Data ultimei actualizări: 03/02/2026

Reprezintă un grant al UE pentru profesori universitari sau lectori superiori oferind un post de predare, cu specializare în studii ale Uniunii Europene.
Data ultimei actualizări: 02/02/2026

Celebrează orașele, comunele și regiunile UE care promovează incluziunea și diversitatea.
Data ultimei actualizări: 01/02/2026

Școală de vară de 10 zile în Germania pentru tineri lideri.
Data ultimei actualizări: 31/01/2026

Apel către studenții de la arte pentru a proiecta primul trofeu oficial al Premiilor New European Bauhaus.
Data ultimei actualizări: 29/01/2026
Apel deschis pentru organizațiile care sprijină lucrătorii aflați în tranziție și care abordează problema deficitului de personal în sectoare strategice.
Data ultimei actualizări: 26/01/2026

Stagii de practică în domeniul industrial pentru studenţii din Uniunea Europeană.
Data ultimei actualizări: 24/01/2026

Programul „Călătorie pentru pace” deschis tinerilor activiști.
Data ultimei actualizări: 18/01/2026

Devino ambasador ONE pentru tineri și contribuie la organizarea de campanii cu impact pentru un viitor mai echitabil.
Data ultimei actualizări: 16/01/2026

Concurs foto și video care se adresează tuturor aplicanților #DiscoverEU.
Data ultimei actualizări: 15/01/2026

Provocare de design pentru tineri, care să creeze proiecte de impact pentru un viitor sustenabil.
Data ultimei actualizări: 15/01/2026

Voluntariat în cadrul unor programe transfrontaliere, transnaționale sau interregionale.
Data ultimei actualizări: 14/01/2026

Comisia Europeană oferă un număr mare de burse pentru absolvenții universităților care provin din țările pentru care se aplica Politica Europeană de Vecinătate (PEV), pentru studii postuniversitare la Colegiul Europa.
Data ultimei actualizări: 14/01/2026

Concurs privind sustenabilitatea mediului deschis studenților din întreaga lume.
Data ultimei actualizări: 06/01/2026

Stagii de practică în domeniul comunicării și în domeniul politicilor și educației la The Good Lobby din Bruxelles.
Data ultimei actualizări: 05/01/2026

Bursă pentru profesioniști din domeniul audiovizualului pentru Programul Nipkow din Berlin.
Data ultimei actualizări: 05/01/2026

Apel pentru festivaluri în vederea sprijinirii artiștilor emergenți din Europa.
Data ultimei actualizări: 04/01/2026

Curs de formare pentru creșterea competențelor organizațiilor internaționale de tineret.
Data ultimei actualizări: 31/12/2025

Apel către organizații și persoane fizice pentru a propune activități, proiecte sau evenimente satelit.
Data ultimei actualizări: 30/12/2025

Burse pentru proiecte care contribuie la implicarea comunității și digitalizarea civică.
Data ultimei actualizări: 23/12/2025

Apel pentru delegații YAS la Comisia pentru statutul femeilor la sediul ONU din New York.
Data ultimei actualizări: 20/12/2025

Întâlniri online cu agenți ai schimbării pentru tineri dornici să aibă un impact social.
Data ultimei actualizări: 12/12/2025

Stagiu în domeniul comunicării la European Alternatives.
Data ultimei actualizări: 10/12/2025

Oportunitate pentru tinerii pasionați de storytelling și creație video.
Data ultimei actualizări: 10/12/2025

Oportunitate pentru organizații conduse de tineri și persoane fizice, instituții și ONG-uri care promovează învățarea despre cetățenia globală.
Data ultimei actualizări: 10/12/2025

Oportunitate pentru tineri între 18 și 30 de ani, pasionați de regiunile de frontieră ale Europei.
Data ultimei actualizări: 10/12/2025

Oportunitate pentru pasionații de cultură și patrimoniu european.
Data ultimei actualizări: 10/12/2025

Oportunitate pentru tineri de a avea un impact real în peisajul intercultural european.
Data ultimei actualizări: 09/12/2025

Centrul Nord-Sud al Consiliului Europei organizează stagii pentru perioade ce variază de la 3 la 6 luni.
Data ultimei actualizări: 08/12/2025

Un curs online gratuit pentru educatori, activiști și tineri.
Data ultimei actualizări: 07/12/2025

Te interesează acțiunile împotriva schimbărilor climatice? Devino ambasador Pact.
Data ultimei actualizări: 07/12/2025

Alătură-te unei conversații despre viitorul oceanelor.
Data ultimei actualizări: 05/12/2025

Program multinaţional de formare intensivă derulat pe o perioadă de 5 săptămâni.
Data ultimei actualizări: 04/12/2025

O bursă pentru tineri profesioniști care doresc să intre în contact cu factorii de decizie politică și să contribuie la modelarea viitorului Europei.
Data ultimei actualizări: 02/12/2025

Stagii remunerate la Agenția Uniunii Europene pentru Azil din Malta.
Data ultimei actualizări: 01/12/2025

Susține cetățenii UE privind studiul afacerilor europene, integrării europene sau al relațiilor SUA – UE.
Data ultimei actualizări: 28/11/2025

Ești un tânăr cineast pasionat de povestiri? Iată șansa ta de a străluci și de a-ți face viziunea cunoscută!
Data ultimei actualizări: 27/11/2025

Oportunități de voluntariat Interreg în Belgia.
Data ultimei actualizări: 25/11/2025

Apel pentru tineri lideri să participe la o reuniune internațională a agenților schimbării din întreaga lume pentru a construi dialogul privind viitorul.
Data ultimei actualizări: 25/11/2025

Alătură-te programului Rotary și acționați pentru a crea schimbări durabile în întreaga lume.
Data ultimei actualizări: 24/11/2025

Apel pentru liderii emergenți care se angajează să găsească soluții la provocările din comunitățile lor.
Data ultimei actualizări: 23/11/2025

Finanțare pentru un masterat în cercetare și inovare în învățământul superior.
Data ultimei actualizări: 19/11/2025

Diferite oportunități de voluntariat în domeniul dezvoltării durabile
Data ultimei actualizări: 19/11/2025

Condiție pentru ca organizațiile să participe la Corpul European de Solidaritate.
Data ultimei actualizări: 17/11/2025

Burse pentru tinerii artiști din familii cu venituri modeste.
Data ultimei actualizări: 07/11/2025

Toți copiii și tinerii cu vârste cuprinse între 5 și 19 ani sunt invitați să-și folosească abilitățile artistice și să arate cum alimentele mai bune creează un viitor mai bun.
Data ultimei actualizări: 03/11/2025

Tinerii cu vârste cuprinse între 16 și 26 de ani, pasionați de cooperarea dintre UE și partenerii săi estici, sunt invitați să devină următorii tineri ambasadori europeni.
Data ultimei actualizări: 03/11/2025

Burse pentru tineri lideri remarcabili pentru a participa la Summitul One Young World în perioada 18-21 septembrie 2024.
Data ultimei actualizări: 31/10/2025

Concursul se adresează studenților din țările ELSA precum și din țările membre ale Consiliului Europei și simulează procedura privind plângerile la Curtea Europeană a Drepturilor Omului.
Data ultimei actualizări: 31/10/2025

Invită tinerii cu vârsta cuprinsă între 13 și 30 de ani din țările eligibile să participe la concurs, să creeze designul unui tricou cu tema Time to Move care prezintă cel mai bine spiritul campaniei.
Data ultimei actualizări: 30/10/2025

Oportunitate pentru liceenii și studenții interesați de o diplomă în străinătate.
Data ultimei actualizări: 23/10/2025

Spațiu pentru tineri de a se implica în acțiunea externă și de cooperare a UE.
Data ultimei actualizări: 16/10/2025

Voluntar online pentru a preda limbi străine (EN/DE/FR) copiilor ucraineni.
Data ultimei actualizări: 15/10/2025

Câștigă o excursie cu toate costurile acoperite pentru a cânta pe scenă la #EYE2025.
Data ultimei actualizări: 14/10/2025

Granturi de cercetare pentru cercetători începători sau avansaţi.
Data ultimei actualizări: 14/10/2025

Concurs pentru elevii de 17 ani, care au astfel ocazia de a vedea ce înseamnă să fii traducător.
Data ultimei actualizări: 14/10/2025

Oportunități la Agenția UE pentru Cooperarea Autorităților de Reglementare în Domeniul Energiei (ACER).
Data ultimei actualizări: 13/10/2025

Apel către liderii media pentru a transforma acoperirea schimbărilor climatice în Europa.
Data ultimei actualizări: 07/10/2025
Oferă absolvenţilor de studii superioare stagii pentru o perioadă cuprinsă între 5 și 9 luni.
Data ultimei actualizări: 30/09/2025

Programul Young Professionals reprezintă o oportunitate unică pentru tinerii care au o pasiune pentru dezvoltarea internaţională şi au şi potenţialul de a deveni lideri globali.
Data ultimei actualizări: 29/09/2025

Oferă toate informațiile esențiale despre programul Corpul European de Solidaritate.
Data ultimei actualizări: 28/09/2025
Granturile permit liderilor de excepție din domeniul cercetării, indiferent de naționalitate și vârstă, să continue proiecte inovatoare, cu risc ridicat, care deschid noi direcții în domeniile lor de cercetare sau în alte domenii. Granturile ERC – Advanced Grants vizează cercetătorii recunoscuți ca cercetători independenți, lideri în domeniul lor de cercetare.
Data ultimei actualizări: 24/09/2025

Sunt premiate proiectele și persoanele care promovează sportul și activitatea fizică.
Data ultimei actualizări: 23/09/2025

Sprijinirea proiectelor care le permit antreprenorilor în curs de afirmare din UE să înveţe într-o companie experimentată dintr-un alt stat membru
Data ultimei actualizări: 04/09/2025

Dorești să împuternicești tinerii în sport? Devino un tânăr delegat ENGSO 2025-2027.
Data ultimei actualizări: 01/09/2025

Oportunități profesionale pentru tinerii absolvenți de universitate.
Data ultimei actualizări: 27/08/2025

Oportunitate pentru femeile în poziții de management de top din domeniul tehnologiei de a obține finanțare, mentorat și coaching.
Data ultimei actualizări: 05/08/2025
Urmăreşte să creeze legături între cetăţeni şi Uniunea Europeană prin furnizarea instrumentelor de promovare a cetăţeniei europene active.
Data ultimei actualizări: 05/08/2025
offers youth-led organisations working in developing countries the opportunity to finance their projects promoting employment, good governance, shelter and secure tenure.
Data ultimei actualizări: 28/07/2025

Oportunitate de a efectua un stagiu de practică la Budapesta pentru proaspeții absolvenți.
Data ultimei actualizări: 20/07/2025

Apel pentru voluntari gata să facă o diferență reală în educația preșcolară.
Data ultimei actualizări: 13/07/2025

Oportunitate pentru tinerii care doresc să facă schimbări, curioși cu privire la modul în care inteligența artificială le poate îmbunătăți munca în mod etic și conștient.
Data ultimei actualizări: 11/07/2025
Oportunitate de a asista la crearea de conținut în limba engleză pentru a fi publicat pe Portalul european pentru tineret, inclusiv pentru canalele de social media.
Data ultimei actualizări: 10/07/2025

Te pasionează educația de calitate? UNESCO caută următoarea sa cohortă de tineri lideri.
Data ultimei actualizări: 07/07/2025

Oportunitate de formare avansată pentru 30 de tineri absolvenți interesați de Uniunea Europeană.
Data ultimei actualizări: 01/07/2025

Cum construiește multilingvismul pacea? Împărtășește-ți povestea și poți câștiga o excursie la Bruxelles!
Data ultimei actualizări: 01/07/2025

Reuniune a tinerilor din zonele rurale și a factorilor de decizie din întreaga Europă.
Data ultimei actualizări: 24/06/2025

Oportunitate pentru lucrătorii din domeniul tineretului de a conecta cercetarea și practica în domeniul politicii de tineret.
Data ultimei actualizări: 24/06/2025

Curs online gratuit privind dialogul intercultural și interconfesional.
Data ultimei actualizări: 24/06/2025

Oportunitate pentru tinerii din zonele rurale pasionați de sensibilizarea și susținerea drepturilor tinerilor din zonele rurale.
Data ultimei actualizări: 24/06/2025

Oportunități de voluntariat Interreg în Belgia.
Data ultimei actualizări: 24/06/2025

Bursă pentru studenții masteranzi comuni în domeniul designului, gestionării orașelor.
Data ultimei actualizări: 24/06/2025

Oportunități pentru tineri absolvenți, studenți postuniversitari sau candidați recent absolvenți.
Data ultimei actualizări: 24/06/2025

Tinerii inovatori din Europa sunt invitați să își prezinte ideile revoluționare.
Data ultimei actualizări: 24/06/2025

Călătorie online de 3 luni cu formare, mentorat pentru extinderea întreprinderilor sociale rurale.
Data ultimei actualizări: 24/06/2025

Împărtășiți modul în care călătoria ta antreprenorială a creat un impact pozitiv și i-a inspirat pe alți tineri.
Data ultimei actualizări: 24/06/2025

Apel pentru artiști care să participe la evenimentul Culture Moves Europe.
Data ultimei actualizări: 24/06/2025

Oportunitate pentru jurnaliști de a explora provocările legate de deșeurile din plastic.
Data ultimei actualizări: 24/06/2025

Pentru tinerii capabili de schimbare să își dezvolte competențele în domeniul drepturilor omului și al emancipării tinerilor.
Data ultimei actualizări: 24/06/2025

Apel către tinerii inovatori pentru a aborda provocările globale legate de apă.
Data ultimei actualizări: 24/06/2025

Apel pentru lideri dinamici gata să modeleze angajamentul NATO față de tineri.
Data ultimei actualizări: 24/06/2025

Apel pentru 11 tineri cu vârsta cuprinsă între 18 și 29 de ani care dețin un card european pentru tineret valabil.
Data ultimei actualizări: 24/06/2025

Vrem să aflăm despre experiența tinerilor în căutarea de informații privind mobilitatea.
Data ultimei actualizări: 24/06/2025

Apel către organizațiile europene de tineret pentru a face parte din Grupul părților interesate din domeniul tineretului din UE
Data ultimei actualizări: 24/06/2025

Participă la consultare, pentru a avea șansa de a câștiga o excursie gratuită la EYE2025.
Data ultimei actualizări: 24/06/2025

Cum te poate ajuta EURES să găsești un loc de muncă echitabil oriunde în Europa?
Data ultimei actualizări: 24/06/2025

Promovează povestirile inovatoare și creative care luptă împotriva schimbărilor climatice.
Data ultimei actualizări: 24/06/2025

Oportunitate pentru tineri de a porni pe o cale de învățare.
Data ultimei actualizări: 24/06/2025

Curs online despre editarea genomului și cercetarea CRISPR.
Data ultimei actualizări: 24/06/2025

Curs online pe teme legate de educație mediatică.
Data ultimei actualizări: 24/06/2025

Apel pentru organizatorii de festivaluri.
Data ultimei actualizări: 24/06/2025

Capturează o acțiune climatică originală!
Data ultimei actualizări: 24/06/2025

Burse pentru jurnaliști de arte emergente.
Data ultimei actualizări: 24/06/2025

Finanțare pentru construirea competențelor de durabilitate în învățământul școlar.
Data ultimei actualizări: 24/06/2025

Seminar de formare pentru sprijinirea tinerilor din Europa și Asia.
Data ultimei actualizări: 24/06/2025

Apel pentru propuneri de granturi UE pentru combaterea șomajului pe termen lung.
Data ultimei actualizări: 24/06/2025

Seminar privind inițiativele pentru tinerii refugiați și migranți.
Data ultimei actualizări: 24/06/2025

Finanțarea pentru recalificarea lucrătorilor în domeniul educației adulților.
Data ultimei actualizări: 24/06/2025

Finanțarea ecosistemelor de microcreditare.
Data ultimei actualizări: 24/06/2025

Finanțarea pentru a crea un mediu de sprijin pentru universitățile din UE.
Data ultimei actualizări: 24/06/2025

Oferi ajutor și primești cazare gratuită.
Data ultimei actualizări: 24/06/2025

Finanțare pentru proiecte de sprijinire a regiunilor ultraperiferice.
Data ultimei actualizări: 24/06/2025

Alătură-te pentru a trăi experiența EYE (European Youth Event) în orașele și regiunile Europei, conectând tineri de pe întreg continentul.
Data ultimei actualizări: 24/06/2025

Apel către tinerii din întreaga Europă să își "ridice nivelul" abilităților de activism.
Data ultimei actualizări: 24/06/2025

Acest program de impact academic al Națiunilor Unite și MCN reunește, provoacă și celebrează implicarea studenților în realizarea obiectivelor ONU.
Data ultimei actualizări: 24/06/2025

Surprinde activismul civic prin obiectivul aparatului tău foto
Data ultimei actualizări: 24/06/2025

Program pentru practicienii pasionați de viitorul Europei.
Data ultimei actualizări: 24/06/2025

Sesiuni și ateliere pe tema artei generative, pentru artiști vizuali la început de drum sau cu experiență.
Data ultimei actualizări: 24/06/2025

Un festival global pentru impact care implică factorii de schimbare din întreaga lume
Data ultimei actualizări: 24/06/2025

Schimb cultural pentru cei care lucrează în vacanță.
Data ultimei actualizări: 24/06/2025

Schimburi de studenți și de candidați la doctorat în cadrul țărilor participante la programul Erasmus+ și către și dinspre țările partenere.
Data ultimei actualizări: 24/06/2025

Un nou program care implică tineri lideri din întreaga lume în activitatea OCDE.
Data ultimei actualizări: 24/06/2025

Un ghid pas cu pas pentru a deveni un factor de schimbare mai eficient.
Data ultimei actualizări: 24/06/2025

Sprijin financiar pentru acțiunile conduse de tineri, menite să promoveze tranziția verde.
Data ultimei actualizări: 24/06/2025

Burse acordate absolvenților din România pentru a urma un program masteral în Germania.
Data ultimei actualizări: 24/06/2025

DAAD oferă proaspeților absolvenți sprijin financiar pentru a studia mai departe în cadrul unei școli doctorale în Germania.
Data ultimei actualizări: 24/06/2025

Data ultimei actualizări: 24/06/2025

Urmărește să aducă UE mai aproape de tineri, să îi încurajeze să devină cetățeni activi și să îi conecteze dincolo de frontiere.
Data ultimei actualizări: 24/06/2025

Oportunitate pentru tineri pasionați de a contribui la combaterea crizei educaționale.
Data ultimei actualizări: 24/06/2025

Oportunitatea de a începe o carieră de creator de conținut în domeniul călătoriilor.
Data ultimei actualizări: 24/06/2025

Recompensează tinerii inovatori care abordează o problemă în cadrul Agendei 2030 pentru Dezvoltare Durabilă ONU.
Data ultimei actualizări: 24/06/2025

Concurs de design social prin care sunt transmise mesaje puternice despre probleme sociale și de mediu.
Data ultimei actualizări: 24/06/2025

Celebrează activitatea fotografiilor de marcă, dar și a celor emergenți.
Data ultimei actualizări: 24/06/2025

Surprinde natura, arată-ți creativitatea și câștigă premii.
Data ultimei actualizări: 24/06/2025

Acțiune națională de vountariat pentru curățarea mediului înconjurător.
Data ultimei actualizări: 24/06/2025

Programul FLEX oferă tinerilor liceeni un an întreg de schimb de experiență în Statele Unite ale Americii.
Data ultimei actualizări: 24/06/2025

Oportunitate pentru tinerii din mediul rural.
Data ultimei actualizări: 24/06/2025

Două poziții sunt deschise prin intermediul Corpului European de Solidaritate.
Data ultimei actualizări: 24/06/2025

Oportunitate pentru studenților interesați de tematica drepturilor omului și de istoria Holocaustului să își aprofundeze cunoștințele deținute.
Data ultimei actualizări: 24/06/2025

Tabără de vară de 3 zile la Atena pentru tinerii profesioniști în domeniul maritim.
Data ultimei actualizări: 24/06/2025

Sprijin financiar pentru copiii și tinerii talentați în sport și artă, care au obținut rezultate foarte bune la concursuri naționale și internaționale în domeniul sportiv sau artistic.
Data ultimei actualizări: 24/06/2025

Apel pentru proiecte pentru a participa la inițiativa Voluntarii Patrimoniului Mondial
Data ultimei actualizări: 24/06/2025

Oportunități la OCDE pentru studenți cu diverse backgrounduri.
Data ultimei actualizări: 24/06/2025

Oportunitate de a contribui la elaborarea politicilor europene de tineret în cadrul Consiliului Europei.
Data ultimei actualizări: 24/06/2025
Eveniment care reunește tineri lideri din întreaga lume.
Data ultimei actualizări: 24/06/2025

Curs online de dezvoltare profesională în lucrul internațional cu tinerii.
Data ultimei actualizări: 24/06/2025

Oportunitate de a câștiga premii în bani și de a beneficia de mentorat pentru transformarea ideilor în afaceri.
Data ultimei actualizări: 24/06/2025

Eveniment public european care aduce cercetătorii mai aproape de public.
Data ultimei actualizări: 24/06/2025

Ajută organizațiile societății civile să promoveze drepturile omului și încurajează participarea tuturor grupurilor la procesele democratice.
Data ultimei actualizări: 24/06/2025

Apel pentru cercetători care vor să se alăture Grupului cercetătorilor europeni în domeniul tineretului (PEYR)
Data ultimei actualizări: 24/06/2025

Oferă participanților „elementele de bază” ale muncii în domeniul tineretului: concepte, definiții, practici, abordări, obiective, actori la nivel european și national.
Data ultimei actualizări: 24/06/2025

Oportunitate pentru tineri de a discuta despre democrație și o societate deschisă.
Data ultimei actualizări: 24/06/2025

Experiență de voluntariat în Lisabona, într-un cartier defavorizat.
Data ultimei actualizări: 24/06/2025

Premiază proiectele și inițiativele care promovează cooperarea și înțelegerea la nivelul UE.
Data ultimei actualizări: 24/06/2025

Oportunitate pentru studenții din ultimul an al unui program de master în interpretare de conferință de a fi invitați la Bruxelles în martie 2020.
Data ultimei actualizări: 24/06/2025

Întâlnești tineri motivați care vor să se implice pentru Europa și descoperi bogăția culturală a Europei alăturându-te unei echipe de peste 300 de voluntari la EYE2025.
Data ultimei actualizări: 24/06/2025

Oportunitate pentru tineri să își împărtășească ideile cu privire la viitorul Europei.
Data ultimei actualizări: 24/06/2025

Platformă de colaborare care îi conectează pe cei care călătoresc cu gazdele lor din întreaga lume unde ei pot călători folosindu-și competențele în schimbul cazării.
Data ultimei actualizări: 24/06/2025

Comitetele naționale IAESTE oferă oportunități de voluntariat studenților și foștilor sau actualilor stagiari IAESTE.
Data ultimei actualizări: 24/06/2025

Celebrează realizările persoanelor și organizațiilor din Europa care le permit oamenilor să exploateze beneficiile și oportunitățile create de transformările digitale.
Data ultimei actualizări: 24/06/2025

Inițiativa oferă oportunități cetățenilor europeni și rezidenților pe termen lung din UE, cu diverse tipuri de experiență profesională, backgrounduri și competențe, pentru a se implica în proiecte de ajutor umanitar
Data ultimei actualizări: 24/06/2025

Invită voluntarii ESC să își împărtășească momentul lor magic în cadrul Corpului European de Solidaritate și să câștige un kit de promovare și un voucher în valoare de 100 de euro.
Data ultimei actualizări: 24/06/2025

Noua inițiativă a Uniunii Europene care le oferă tinerilor șansa de a face voluntariat sau de a se implica în proiecte (în propria țară sau în străinătate) pentru a ajuta comunități și oameni din toată Europa
Data ultimei actualizări: 24/06/2025
participă și împărtășește ce înseamnă cinci pentru tine: care sunt cele cinci priorități ale tale, cele mai importante cinci dorințe, cinci lucruri frumoase, cinci prieteni, animale de companie, locuri preferate... ai șansa să câștigi o călătorie la Bruxelles, Belgia.
Data ultimei actualizări: 24/06/2025

Conferință pentru tineri de o săptămână, care urmărește simularea procesul decizional în cadrul UE.
Data ultimei actualizări: 24/06/2025
The specific objective of this call is to to promote health-enhancing physical activity (HEPA) to refugees.
Data ultimei actualizări: 24/06/2025
AFCN - Administraţia Fondului Cultural Naţional a lansat apelul naţional pentru Concursul de proiecte culturale - Sesiunea II 2016
Data ultimei actualizări: 24/06/2025
Data ultimei actualizări: 24/06/2025
Dezvoltarea proiectelor transnaționale, structurate, orientate către rezultat între instituțiile de învățământ superior și mediul de afaceri
Data ultimei actualizări: 24/06/2025
The award invites science journalists at the beginning of their career, with a maximum of 5 years’ experience, to submit an article on the main topic of Global Health.
Data ultimei actualizări: 24/06/2025
to assess the value of sport in EU external policies, and in public diplomacy in particular.
Data ultimei actualizări: 24/06/2025
seeks to highlight creative and inspiring visual answers to this crucial question: How can individuals be empowered to improve their lives and contribute to the democratic development of their communities and countries through entrepreneurship?
Data ultimei actualizări: 24/06/2025

Oferă tinerilor specialişti cu înaltă calificare din statele membre ale UE oportunitatea de a lucra în cadrul delegaţiilor Uniunii Europene.
Data ultimei actualizări: 24/06/2025

Invită tinerii economiști să scrie despre politica comercială și comerțul internațional
Data ultimei actualizări: 24/06/2025

Urmărește să evidențieze și să susțină cele mai bune soluții de inovare socială.
Data ultimei actualizări: 24/06/2025
Young people worldwide, from 13 to 24 years old, are invited to make their voices heard in the dialogue on addressing global poverty by making a video answering the question “If you could have your say, how would you fight poverty?”.
Data ultimei actualizări: 24/06/2025
encourages young people from around the world to creatively express their vision for driving positive change in local communities through photo essays, music videos and other forms of visual storytelling.
Data ultimei actualizări: 24/06/2025
este o subvenție UE dedicată instituțiilor care sporesc activitățile și formarea profesorilor pe teme ale Uniunii Europene, la nivel postuniversitar și/sau pentru alte părți interesate.
Data ultimei actualizări: 24/06/2025
supports any public or private organisation active in the field of adult education, in the labour market or in the fields of education, training and youth, to organise projects promoting the mobility of adult education staff in another country.
Data ultimei actualizări: 24/06/2025
inspirat de anul 2015 - Anul european pentru dezvoltare, tinerii cetățeni talentați din UE, cu vârsta peste 18 ani, pot trimite fotografiile lor pe o temă lunară, până în luna septembrie 2015
Data ultimei actualizări: 24/06/2025
participants have to create a short video clip, between 30 seconds to 1 minute, on the theme “European citizens”.
Since the year 2013 is the European year for "European citizens", it is also the theme of this year’s edition. What does it mean to be European? How do you feel about being a citizen of the European Union?
Data ultimei actualizări: 24/06/2025
Data ultimei actualizări: 24/06/2025

Acest program își propune să ofere cunoașterea Agenției, precum și a rolului acesteia în cadrul activităților Uniunii Europene.
Data ultimei actualizări: 24/06/2025

O oportunitate pentru instituțiile de învățământ superior de a crea programe de studiu internaționale pentru studenți la nivel de masterat și de a acorda burse.
Data ultimei actualizări: 24/06/2025
supports the organisation of European Voluntary Service activities, involving minimum 30 volunteers, in the framework of European or worldwide events in the field of youth, culture and sport including conferences, seminars, meetings and workshops.
Data ultimei actualizări: 24/06/2025
invites any citizen over 18 years to make a short video promoting the benefits of the Europass initiative and get the chance to win a trip in a dream city in Europe and cash prizes.
Data ultimei actualizări: 24/06/2025
The competition gives European university students and young professionals under 27 a chance to create an app and turn it into a business.
Data ultimei actualizări: 24/06/2025
promotes the role web entrepreneurs play in European society and encourages and inspires potential entrepreneurs.
Data ultimei actualizări: 24/06/2025

Tabără de vară pentru tineri cu vârsta cuprinsă între 17 şi 20 de ani.
Data ultimei actualizări: 24/06/2025
Concursul caută filmuleţe creative şi originale cu experienţe de mobilitate.
Data ultimei actualizări: 24/06/2025

Premiul CESE recunoaște în fiecare an excelența în domeniul inițiativelor societății civile.
Data ultimei actualizări: 24/06/2025
Creative Encounters: parteneriat cultural între Asia şi Europa este o nouă iniţiativă care urmăreşte să sprijine proiectele artistice în colaborare în contextul dialogului Asia-Europa.
Data ultimei actualizări: 24/06/2025

Invită tinerii din zona euro-mediteraneană să își prezinte poveștile.
Data ultimei actualizări: 24/06/2025
Fonduri pentru crearea unei platforme europene online pentru profesori în domeniul educaţiei antreprenoriale.
Data ultimei actualizări: 24/06/2025
Premiul promovează studiile în domeniile legate de dreptul muncii.
Data ultimei actualizări: 24/06/2025
Competiţie de eseuri pe tema "Generaţia viitoare a antreprenorilor "verzi""
Data ultimei actualizări: 24/06/2025

Permite persoanelor din sectorul industrial din Europa să îşi îmbunătăţească abilităţile de a comunica în afaceri cu parteneri din Japonia, de la interacţiuni în domeniul comerţului până la cele în domeniul cercetării.
Data ultimei actualizări: 24/06/2025

Promovează cercetarea academică în domeniile politicilor culturale și managementului cultural.
Data ultimei actualizări: 24/06/2025
Stagii plătite pe o perioadă de cinci luni pentru persoanele cu dizabilităţi. Aceste stagii se adresează atât absolvenţilor de studii superioare, cât şi celor care au calificări sub acest nivel.
Data ultimei actualizări: 24/06/2025
Finanţează propuneri pentru activităţi şi iniţiative care susţin dialogul intercultural în cele 37 de state Euro-mediteraneene.
Data ultimei actualizări: 24/06/2025

Program al Parlamentului European menit să ofere elevilor o perspectivă din interior asupra modului în care se derulează activitatea în cadrul Parlamentului European.
Data ultimei actualizări: 10/06/2025

Explorează rolul cercetării în domeniul tineretului în modelarea politicilor bazate pe dovezi și a practicilor de lucru cu tinerii.
Data ultimei actualizări: 02/06/2025

Împărtășește-ți ideile pentru a combate dezinformarea electorală.
Data ultimei actualizări: 02/06/2025

Burse pentru studenții din învățământul superior.
Data ultimei actualizări: 03/05/2025

Oportunitate de a contribui la derularea campaniilor de comunicare și transformarea conceptelor în materiale (audio)vizuale.
Data ultimei actualizări: 30/04/2025

Oportunitate pentru tinerii rezidenți în UE de a câștiga o excursie la EYE2023.
|
Contribuie la schimbare și reprezintă interesele tinerilor din România la nivel internațional!
Înscrie-te și adu în prim-plan schimbările pe care le-ai generat în comunitatea ta!
Contribuie la schimbare și reprezintă interesele tinerilor din România la nivel internațional!
Înscrie-te și adu în prim-plan schimbările pe care le-ai generat în comunitatea ta!